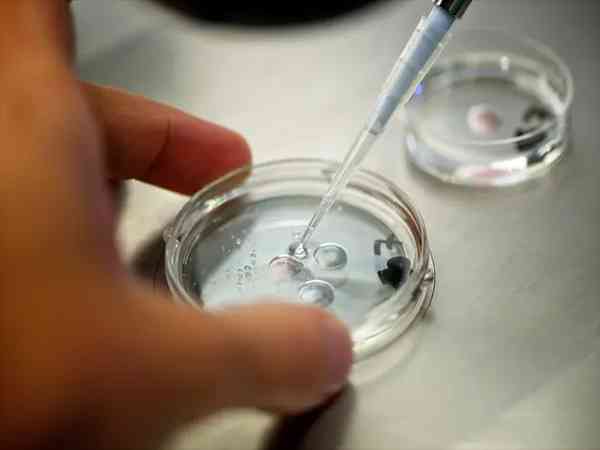

乳腺癌患者服用來曲唑片第5天出現3個優勢卵泡是正常反應嗎?
吃來曲唑片五天出現3個卵泡是正常的,來曲唑片主要成分為來曲唑,有促進卵泡發育排出的作用,所以出現多個優勢卵泡屬於正常的現象,通常一次促排會出現多個卵泡,臨床目的也是為尋找優勢卵泡,因此患者的情況屬於比較好的結果,無需過於擔心。來曲唑片是一個... 全文

何麗玲

優勢卵泡與子宮內膜薄,促排期間的挑戰與對策
如果僅卵泡期內膜薄不影響備孕,排卵後內膜仍薄,需要先將內膜調理到正常的厚度才可以進行備孕,子宮內膜厚度在月經週期不同時間段的厚度也不同,月經剛乾淨內膜薄是正常的,如果排卵後尤其是受精卵著床時間段內膜薄會影響受孕,需要給予治療後再備孕。一般超... 全文

二人牽手是知音

優勢卵泡老是在一側排卵有三種原因,單側隨機現象是其一
優勢卵泡老在一側是因為隨機排卵、多囊卵巢、輸卵管堵塞造成的。女性的排卵是隨機的,有時候也會出現單側排卵的情況,如果女性患有多囊卵巢也會造成單側排卵,另外如果女性有婦科炎症或宮腔操作史也容易形成輸卵管單側積液堵塞,卵子就會從通暢的一邊排出。育... 全文

猴皮筋

從無優勢卵泡到備孕成功,全靠中藥+調經促孕丸實現逆風翻盤
有過一次自然流產,後做檢查,查出抗體陽性,治療一個月後轉陰。隔了兩個月開始備孕,結果監測到無優勢卵泡,我就搜關於長泡泡的方法,接下來就是抱著反正中藥吃不死人的想法自己去藥店抓藥,喝好孕湯,後面又加上調經促孕丸,沒想到我的優勢卵泡它就真的來了... 全文

夏初遇見愛

月經不調懷疑是多囊,歪打正著測出優勢卵泡懷了
10月份和老公訂婚後就呆一起,從那以後,我就想開始備孕,但是三個月後都沒有成功,後面去醫院看說我的黃體偏高,需要調理月經,讓促黃體跟卵泡的差值是1。在吃過一個月後我就在月經第五天吃克米促排,因為感覺白帶很多,無意測了一下,結果意料之外,左邊... 全文

未見面就說再見

短方案促排後屬於優質卵子範圍的大小說明!
促排後優質的卵子一般都是1.8-2.5cm左右,有0.2mm左右的浮動,在這個範圍的卵子一般都是優質卵子,但是也不能僅僅按照卵子的大小來判斷卵子的好壞,因為一些成熟的卵子有可能是空卵泡,取卵後也沒有辦法正常使用,但是通常情況下空卵泡發育不到... 全文

高地折耳貓

一文說清竇卵泡形成卵泡時長,兩種情況所需時間不一樣
竇卵泡要十天左右才能夠發育為優勢卵泡。竇卵泡是基礎卵泡的一種形式,小於10mm的竇卵泡一天生長速度為1.5mm-2mm,由此推斷需要十天左右的時間才能發育為優勢的卵泡,不過這是在女性身體不存在任何問題的情況,如果女性有排卵障礙或者其他影響卵... 全文

檸檬物語

微刺激方案下每日150單位賀美奇對卵泡發育均勻性的影響研究
不僅是微刺激方案促排卵泡可能發育不均勻,採用其他促排方案都可能出現卵泡發育不均勻的情況,卵泡不均勻指卵泡發育大小不一,有大有小,甚至還有空泡的情況,這主要與患者的年齡、卵巢功能等有關,但只要有優勢卵泡發育,能獲取到可用的卵子,那麼促排就是成... 全文

幸福使者
基礎卵泡8個,使用來曲唑促排後數量會增加嗎?
基礎卵泡8個用來曲唑促排後可能會增多,因為促排的主要作用就是獲得更多的卵泡,但是也有可能不會增多,促排有可能只會讓這8個卵泡儘可能多的發育成熟,發育成健康的的優勢卵泡,促排過程就是通過使用外源性激素藥物將本該凋亡的卵泡,讓其繼續發育,獲得更... 全文

千與千尋

卵泡22mm打完夜針後取卵時間一定要安排在36h內?
打完夜針必須在36小時之內取卵,但如果時間間隔超過36小時,則有可能一部分卵泡可能會成熟排出,不容易取卵,其實在24-36小時之間只要卵泡發育成熟了就能夠取卵了,而且如果取卵時間與夜針間距低於35小時,卵泡22mm則很有可能未熟,這時候卵子... 全文

蔡紅梅

降調後首次抽血查卵泡刺激素的正常值範圍是多少?
降調後第一次抽血檢查卵泡刺激素8-10mU/mL是比較正常的,如果降調後卵泡刺激素不正常那麼就需要繼續降調,否則可能會影響到促排卵時候的卵泡發育,促卵泡激素控制著分泌卵泡液、選擇優勢卵泡以及閉鎖退化非優勢卵泡等等作用,所以降調後卵泡刺激素是... 全文

百變小櫻

多大的卵泡才能配上夜針?這個問題終於有答案了
在試管嬰兒手術中過程中,最關鍵的並不是移植或者著床,按照醫生的話來說最需要注意的就是促排環節,因為促排後優勢卵泡數量關係到成功率,而對於促排環節來說最需要注意的就是打夜針階段。那麼,試管嬰兒卵泡多大可以打夜針呢?試管嬰兒注射夜針的原因通常來... 全文

山青青水藍藍
